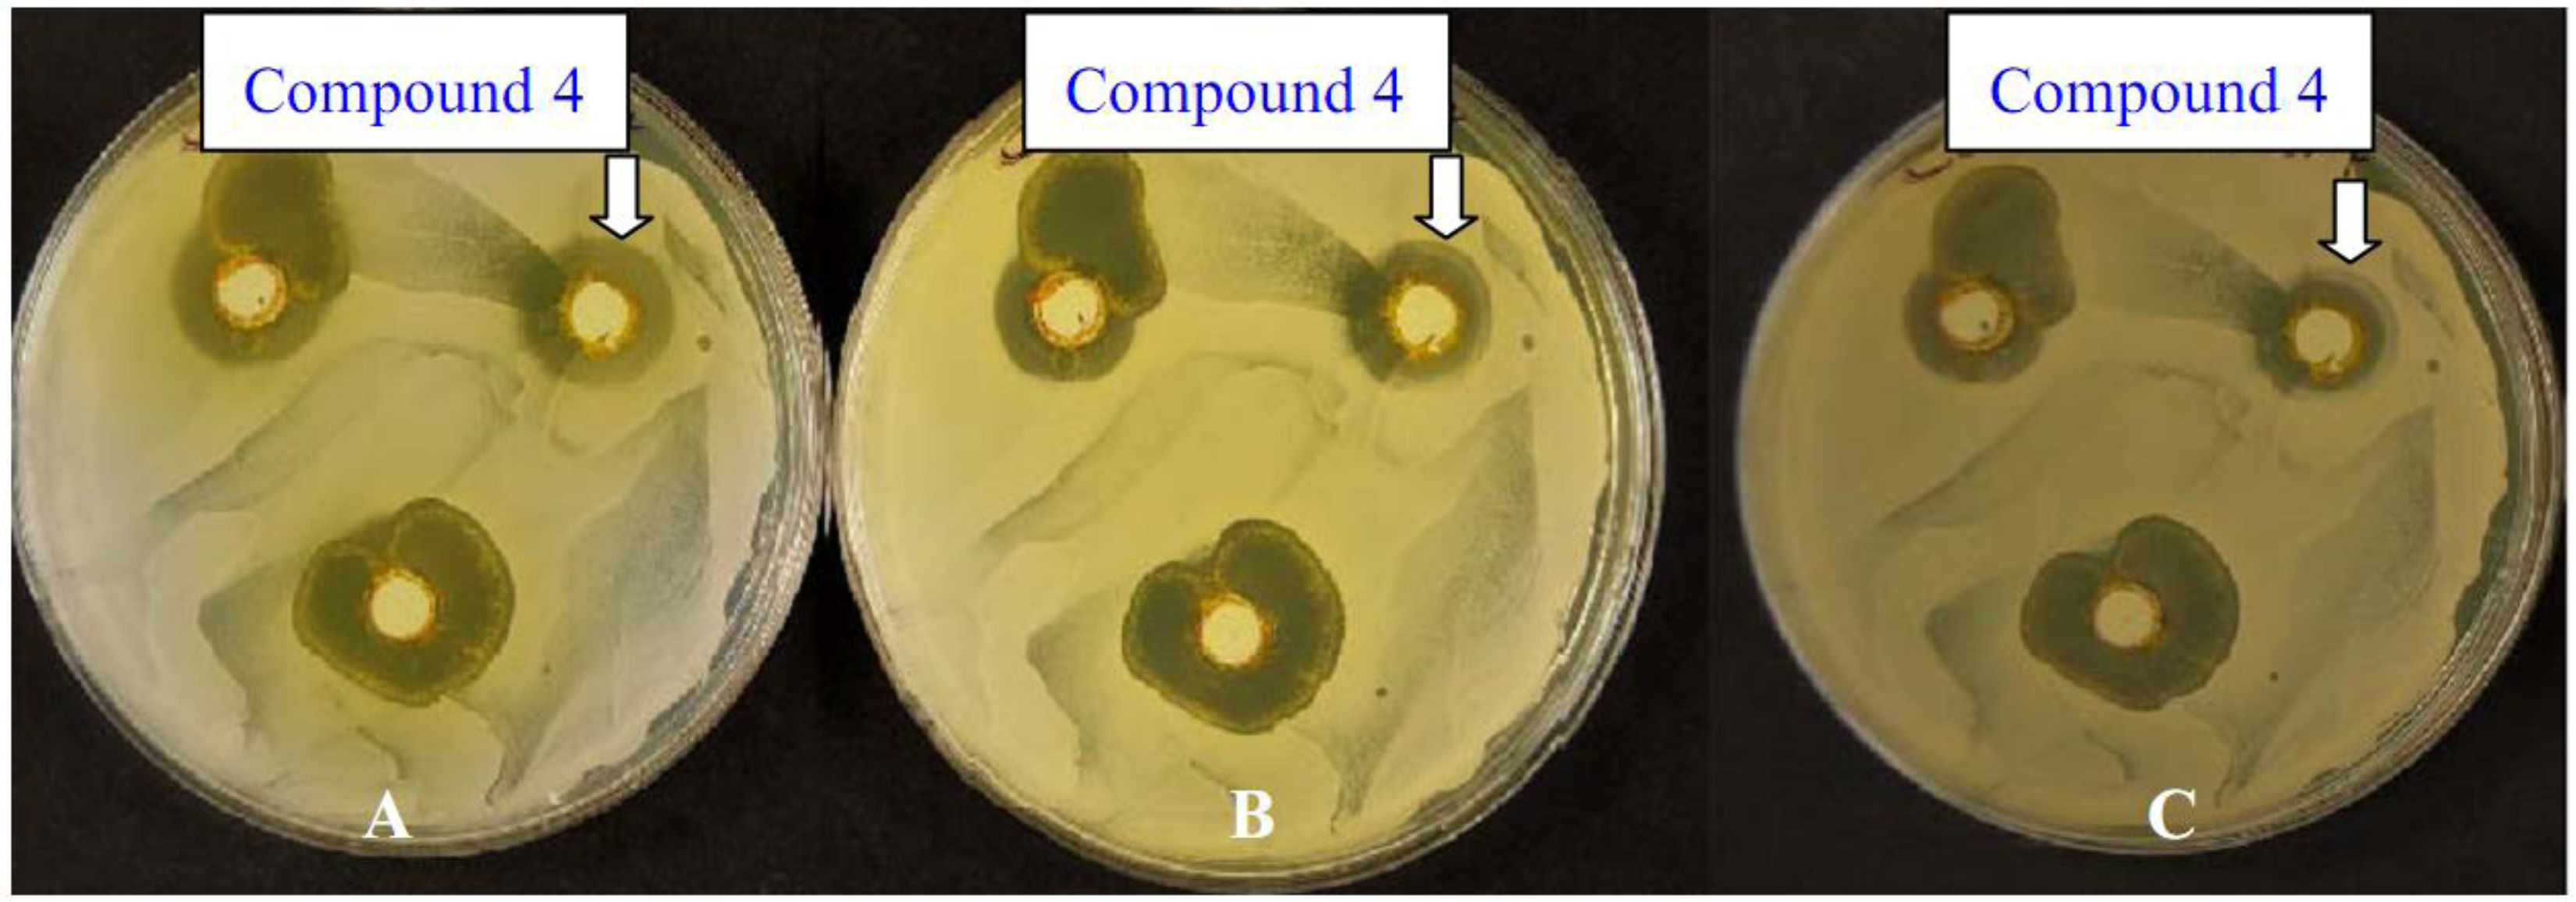

One-Pot Synthesis of Disperse Dyes Under Microwave Irradiation: Dyebath Reuse in Dyeing of Polyester Fabrics
Abstract
:1. Introduction
2. Results and Discussion
2.1. Synthesis






2.2. Dyeing
| Dye No | Color shade on polyester | Color strength (K/S) % Dye o.m.f. | |||||
|---|---|---|---|---|---|---|---|
| 1 | 2 | 3 | 4 | 5 | 6 | ||
| 5 | Yellowish-orange | 1.17 | 2.12 | 2.47 | 2.49 | 4.25 | 4.66 |
| 7 | Pale orange | 2.19 | 3.79 | 4.09 | 6.71 | 6.91 | 6.96 |
| 11a | Dark orange | 5.66 | 5.95 | 7.12 | 8.31 | 10.30 | 10.57 |
| 11b | Dark orange | 5.43 | 5.81 | 7.91 | 8.48 | 10.04 | 12.89 |
| 11c | Orange | 4.40 | 4.64 | 4.85 | 6.01 | 6.25 | 6.56 |
| 11d | Orange | 4.08 | 4.73 | 6.02 | 7.06 | 7.47 | 8.85 |
| Dye No | Color shade on polyester | Color strength (K/S) % Dye o.m.f. | |||||
|---|---|---|---|---|---|---|---|
| 1 | 2 | 3 | 4 | 5 | 6 | ||
| 5 | Yellowish-orange | 1.02 | 1.67 | 2.42 | 2.09 | 3.28 | 3.99 |
| 7 | Pale orange | 2.12 | 3.56 | 4.08 | 5.70 | 5.77 | 6.79 |
| 11a | Dark orange | 4.76 | 5.47 | 5.56 | 6.20 | 6.89 | 8.78 |
| 11b | Dark orange | 3.06 | 3.99 | 4.30 | 4.76 | 6.66 | 8.59 |
| 11c | Orange | 3.45 | 3.54 | 3.48 | 4.35 | 4.55 | 5.41 |
| 11d | Orange | 2.59 | 3.95 | 4.17 | 5.63 | 6.44 | 8.28 |
| Dye | Dye o.m.f. % | Wash fastness | Perspiration fastness | Light fastness | |||||||
|---|---|---|---|---|---|---|---|---|---|---|---|
| Alkaline | Acidic | ||||||||||
| Alt | SC | SW | Alt | SC | SW | Alt | SC | SW | |||
| 5 | 1% | 5 | 5 | 5 | 5 | 5 | 5 | 5 | 5 | 5 | 3–4 |
| 7 | 5 | 5 | 5 | 5 | 5 | 5 | 5 | 5 | 5 | 2 | |
| 11a | 5 | 5 | 5 | 5 | 5 | 5 | 5 | 5 | 5 | 3 | |
| 11b | 5 | 5 | 5 | 5 | 5 | 5 | 5 | 5 | 5 | 2–3 | |
| 11c | 4–5 | 4 | 4–5 | 5 | 5 | 4–5 | 5 | 5 | 5 | 2–3 | |
| 11d | 4–5 | 4–5 | 4–5 | 5 | 5 | 5 | 5 | 5 | 5 | 2–3 | |
| 5 | 2% | 5 | 5 | 5 | 5 | 5 | 5 | 5 | 4 | 5 | 4 |
| 7 | 5 | 5 | 5 | 5 | 5 | 5 | 5 | 5 | 5 | 2 | |
| 11a | 5 | 5 | 5 | 5 | 5 | 5 | 5 | 5 | 5 | 2–3 | |
| 11b | 5 | 5 | 5 | 5 | 5 | 5 | 5 | 4 | 5 | 3 | |
| 11c | 4–5 | 4 | 4–5 | 5 | 5 | 5 | 4–5 | 4–5 | 4–5 | 2–3 | |
| 11d | 4–5 | 4–5 | 4–5 | 5 | 5 | 5 | 5 | 5 | 5 | 2–3 | |
| 5 | 3% | 5 | 5 | 5 | 5 | 5 | 5 | 5 | 5 | 5 | 3–4 |
| 7 | 5 | 5 | 5 | 5 | 5 | 5 | 5 | 5 | 5 | 2–3 | |
| 11a | 4–5 | 4–5 | 4–5 | 5 | 5 | 5 | 5 | 4–5 | 5 | 2–3 | |
| 11b | 5 | 4–5 | 4–5 | 5 | 5 | 5 | 5 | 5 | 5 | 3 | |
| 11c | 4–5 | 4–5 | 4–5 | 5 | 5 | 5 | 5 | 5 | 5 | 2–3 | |
| 11d | 4–5 | 4 | 4–5 | 5 | 5 | 5 | 5 | 5 | 5 | 2–3 | |
| 5 | 4% | 5 | 5 | 5 | 5 | 5 | 5 | 5 | 5 | 5 | 4 |
| 7 | 5 | 4 | 4 | 5 | 5 | 5 | 5 | 5 | 5 | 2–3 | |
| 11a | 5 | 5 | 5 | 5 | 5 | 5 | 5 | 5 | 5 | 2–3 | |
| 11b | 5 | 5 | 5 | 5 | 5 | 5 | 5 | 5 | 5 | 3–4 | |
| 11c | 5 | 4–5 | 4–5 | 5 | 4–5 | 5 | 5 | 5 | 5 | 2–3 | |
| 11d | 5 | 4–5 | 4–5 | 4–5 | 4–5 | 5 | 4–5 | 4–5 | 5 | 2 | |
| 5 | 5% | 5 | 5 | 5 | 5 | 5 | 5 | 5 | 5 | 5 | 4–5 |
| 7 | 5 | 5 | 5 | 5 | 5 | 5 | 5 | 5 | 5 | 2–3 | |
| 11a | 5 | 4–5 | 4–5 | 5 | 5 | 5 | 5 | 5 | 5 | 3 | |
| 11b | 5 | 5 | 5 | 5 | 5 | 5 | 5 | 5 | 5 | 2–3 | |
| 11c | 4–5 | 4–5 | 4–5 | 5 | 5 | 5 | 5 | 5 | 5 | 2–3 | |
| 11d | 5 | 4 | 4 | 5 | 5 | 4–5 | 5 | 5 | 5 | 3 | |
| 5 | 6% | 5 | 5 | 5 | 5 | 5 | 5 | 5 | 5 | 5 | 4 |
| 7 | 5 | 5 | 5 | 5 | 5 | 5 | 5 | 5 | 5 | 2–3 | |
| 11a | 4–5 | 4–5 | 4–5 | 5 | 4–5 | 5 | 5 | 4–5 | 5 | 2–3 | |
| 11b | 4–5 | 4–5 | 4–5 | 5 | 4–5 | 5 | 5 | 5 | 5 | 3–4 | |
| 11c | 4–5 | 4–5 | 4–5 | 5 | 5 | 5 | 5 | 5 | 5 | 3 | |
| 11d | 4–5 | 4 | 4–5 | 5 | 5 | 4–5 | 5 | 5 | 5 | 3 | |
2.2.1. Color Strength
2.2.2. Color Fastness
2.3. Antimicrobial Activities
| Compound number | Inhibition zone diameter (Nearest mm) | |||||
|---|---|---|---|---|---|---|
| prokaryotic organisms | eukaryotic organisms | |||||
| B. subtilus | S. aureus | E. coli | Serratia sp. | C. albicans | S. cerevisiae | |
| Mean ± SD | Mean ± SD | Mean ± SD | Mean ± SD | Mean ± SD | Mean ± SD | |
| Strong antimicrobial | ||||||
| 4 | 11(0.1) | 13(0.3) | NI | 4 (0.1) | 8(0.3) | 1(0.3) |
| 5 | 11(0.2) | 12(0.1) | NI | NI | 1(0.2) | NI |
| Moderate antimicrobial | ||||||
| 11a | 7(0.2) | 7(0.2) | NI | NI | 1(0.1) | NI |
| Weak antimicrobial | ||||||
| 7 | 4(0.2) | NI | NI | NI | 4(0.1) | NI |
| 11b | 2(0) | NI | NI | NI | 2(0.1) | NI |
| 11c | 2(0) | NI | NI | 2(0.1) | 3(0.2) | NI |
| 11d | 2(0) | 3(0.1) | NI | NI | 3(0.2) | 1(0.1) |
| Ampicillin* | 7 | 30 | 15 | 26 | ||
| Cyloheximide** | NI | 30 | ||||

3. Experimental
3.1. General
3.2. General Procedure for the Synthesis of Azo Disperse Dyes
3.3. High Temperature Dyeing Method (HT)
3.3.1. Materials
3.3.2. Dyeing
3.3.3. Dyebath Reuse Procedure
3.4. Color Measurements and Analyses
3.4.1. Color Measurements of the Dyed Fabrics
3.4.2. Fastness Testing
3.5. Antimicrobial Activities Test
4. Conclusions
Acknowledgments
References and Notes
- Neamtu, M.; Yediler, A.; Siminiceanu, I.; Macoveanu, M.; Kettrup, A. Decolorization of disperse red 354 azo dye in water by several oxidation processes—A comparative study. Dyes Pigm. 2003, 60, 61–68. [Google Scholar]
- Perkins, W.S.; Walsh, W.K.; Reed, I.E.; Namboodri, C.G. A demonstration of reuse of spent dyebath water following color removal with ozone. Text. Chem. Color. 1995, 28, 31–37. [Google Scholar]
- Vandevivere, P.C.; Bianchi, R.; Verstraete, W. Treatment and reuse of wastewater from the textile wet processing industry: Review of emerging technologies. J. Chem. Technol. Biotechnol. 1998, 72, 289–309. [Google Scholar]
- Lopez, A.; Ricco, G.; Ciannarella, R.; Rozzi, A.; Dipinto, A.C.; Passino, R. Textile wastewater reuse: Ozonation of membrane concentrated secondary effluent. Water Sci. Technol. 1999, 40, 99–105. [Google Scholar]
- Ciardelli, G.; Capannelli, G.; Bottino, A. Ozone treatment of textile wastewaters for reuse. Water Sci. Technol. 2001, 44, 61–67. [Google Scholar]
- Muthukumar, M.; Sargunamani, D.; Senthilkumar, M.; Selvakumar, N. Studies on decoloration, toxicity and the possibility for recycling of acid dye effluents using ozone treatment. Dyes Pigm. 2005, 64, 39–44. [Google Scholar]
- Agudelo, C.; Lis, M.; Valldeperas, J.; Sato, T. Fabric color changes in polyester micro-fibers caused by the multiple reuse of dispersed-dyes dye baths: Part 1. Text. Res. J. 2008, 78, 1041–1047. [Google Scholar]
- Agudelo, C.; Lis, M.; Valldeperas, J.; Sato, T. Fabric color changes in polyester micro-fibers caused by the multiple reuse of dispersed-dyes dye baths. Part II. Text. Res. J. 2009, 79, 326–336. [Google Scholar] [CrossRef]
- Koh, J.S.; Kim, Y.G.; Kim, J.P. Dyebath reuse in dyeing of nylon microfiber non-woven fabric with 1:2 metal complex dyes. Fiber. Polym. 2001, 2, 35–40. [Google Scholar]
- Koh, J.; Cho, J.; Kim, J. Dyebath reuse in dyeing of nylon microfiber nonwoven fabrics with binary mixtures of 1:2 metal complex. AATCC Rev. 2001, 1, 27–30. [Google Scholar]
- Ji, J.-L.; Yang, X.-J.; Lu, L.-D.; Wang, X. Studies on the possibility of recycling microencapsulated disperse dye-bath effluents. J. Appl. Poly. Sci. 2009, 113, 3774–3781. [Google Scholar]
- Kale, M.J.; Bhat, N.V. Effect of microwave pretreatment on the dyeing behavior of polyester fabric. Color. Technol. 2011, 127, 365–371. [Google Scholar]
- El-Apasery, M.A. Solvent-free one-pot synthesis of some azo disperse dyes under microwave irradiation: Dyeing of polyester fabrics. J. Appl. Poly. Sci. 2008, 109, 695–699. [Google Scholar]
- El-Apasery, M.A. Synthesis of some azo disperse dyes by the use of focused microwave heating. Pol. J. Appl. Chem. 2006, 50, 75–81. [Google Scholar]
- Al-Etaibi, A.M.; Al-Awadi, N.A.; El-Apasery, M.A.; Ibrahim, M.R. A facile synthesis of new monoazo disperse dyes derived from 4-hydroxyphenylazopyrazole-5-amines: Evaluation of microwave assisted dyeing behavior. Color. Technol. 2012. submitted.. [Google Scholar]
- Al-Etaibi, A.M.; Al-Awadi, N.A.; El-Apasery, M.A.; Ibrahim, M.R. Synthesis of some novel pyrazolo[1,5-a]pyrimidine derivatives and their application as disperse dyes. Molecules 2011, 16, 5182–5193. [Google Scholar]
- Crystallographic data for the structures of compounds 4, 7 and 11c reported in this paper have been deposited with the Cambridge Crystallographic Data Centre as supplementary publications Nos. 848619, 848620 and 871092. These data can be obtained free of charge from the Cambridge Crystallographic Data Centre via http://www.ccdc.cam.ac.uk.
- Zanella, G.; Scharf, M.; Vieira, G.A.; Peralta-Zamora, P. Treatment of textile dyeing baths by photo-Fenton processes and evaluation of reuse. Quim. Nova 2010, 33, 1039–1043. [Google Scholar]
- Ji, J.; Yang, X.; Lu, L.; Wang, X. Studies on the possibility of recycling microencapsulated disperse dye-bath effluents. J. Appl. Pol. Sci. 2009, 113, 3774–3781. [Google Scholar]
- Agudelo, C.A.; Lis, M.J.; Valldeperas, J.; Navarro, J.A. Disperse dyeing via direct reutilization bath: Polyester microfibers. Boletin Intexter del Instituto de Investigacion Textil y de Cooperacion Industrial 2006, 129, 13–20. [Google Scholar]
- Agudelo, C.A.; Lis, M.J.; Valldeperas, J.; Navarro, J.A. Dyeing kinetics in direct reutilization baths: Polyester microfibers with disperse dyes. Rev. Quim. Textil 2004, 166, 42-44, 46-48. [Google Scholar]
- Zhang, Z.-T.; Ma, Y.-Q.; Liang, Y.; Xue, D.; He, Q. An efficient one-pot synthesis of diarylpyrazolo[1,5-a]pyrimidine from isoflavones. J. Heterocycl. Chem. 2011, 48, 279–285. [Google Scholar]
- Chrysler, L.P. Methods of Test for Color Fastness of Textiles and Leather, 7th ed; Bradford: London, UK, 1990; pp. 89–94. [Google Scholar]
- EI-Apasery, M.A.; Al-Mousawi, S.M.; Mahmoud, H.; Elnagdi, M.H. Novel routes to biologically active enaminones, dienoic acid amides, arylazonicotinates and dihydropyridazines under microwave irradiation. Int. Res. J. Pure Appl. Chem. 2011, 1, 69–83. [Google Scholar]
- Sample Availability: Samples of compounds 4, 5, 7 and 11a–d are available from the authors.
© 2012 by the authors; licensee MDPI, Basel, Switzerland. This article is an open-access article distributed under the terms and conditions of the Creative Commons Attribution license (http://creativecommons.org/licenses/by/3.0/).
Share and Cite
Al-Etaibi, A.M.; El-Apasery, M.A.; Mahmoud, H.M.; Al-Awadi, N.A. One-Pot Synthesis of Disperse Dyes Under Microwave Irradiation: Dyebath Reuse in Dyeing of Polyester Fabrics. Molecules 2012, 17, 4266-4280. https://doi.org/10.3390/molecules17044266
Al-Etaibi AM, El-Apasery MA, Mahmoud HM, Al-Awadi NA. One-Pot Synthesis of Disperse Dyes Under Microwave Irradiation: Dyebath Reuse in Dyeing of Polyester Fabrics. Molecules. 2012; 17(4):4266-4280. https://doi.org/10.3390/molecules17044266
Chicago/Turabian StyleAl-Etaibi, Alya M., Morsy A. El-Apasery, Huda M. Mahmoud, and Nouria A. Al-Awadi. 2012. "One-Pot Synthesis of Disperse Dyes Under Microwave Irradiation: Dyebath Reuse in Dyeing of Polyester Fabrics" Molecules 17, no. 4: 4266-4280. https://doi.org/10.3390/molecules17044266
APA StyleAl-Etaibi, A. M., El-Apasery, M. A., Mahmoud, H. M., & Al-Awadi, N. A. (2012). One-Pot Synthesis of Disperse Dyes Under Microwave Irradiation: Dyebath Reuse in Dyeing of Polyester Fabrics. Molecules, 17(4), 4266-4280. https://doi.org/10.3390/molecules17044266
